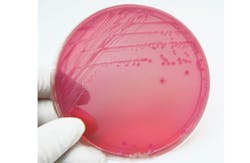
Linde Stewart/Thinkstock Linde Stewart/Thinkstock

What it is:
- Coliform bacteria (common designation: Total coliforms) are rod-shaped, gram-negative, non spore-forming bacteria that can ferment lactose with the production of acid and gas when incubated for 24 hours at 35°-37° C.
- Coliforms are found in water, soil and on vegetation and in feces of warm blooded animals. There are numerous genera included in the group called coliforms. Some of them are Citrobacter, Enterobacter, Hafnia, Klebsiella, Serratia.
- Fecal coliforms and Eschericia coli (E. coli) are also rod-shaped, gram-negative organisms. Fecal coliforms and E. coli can ferment lactose at 44° C in ~ 48 hours (12-72 hours) and produce acid and gas. The optimum growth temperature for E.coli is 37° C.
- The presence of fecal coliforms or E. coli is a more specific indicator of fecal contamination than total coliforms alone. E.coli rod dimensions are approximately 2 µm (microns) in length by 0.5 µm width. Even E.coli are not a single bacterium and there are numerous strains.
- The name Eschericia coli is derived from Theodor Eschereich who discovered them in 1885 in the feces from colons of healthy people.
Occurrence:
- Total coliforms are common environmental organisms in soils and water as well as being found in fecal sources from warm blooded animals.
- They are common in surface water, soils, plant materials and paper mill effluents. For that reason detections of total coliforms alone are not a clear indicator of fecal contamination, whereas the presence of fecal coliforms or E. coli is a much more specific marker of fecal contamination. This is especially true for E. coli, although even they are not completely unique in that regard because some have been found in environmental samples in warm climates.
Health effects:
- Total coliforms and bacteria in the genus E. coli are usually not pathogens per se. Most strains of E. coli are harmless, but some can cause serious illness in humans such as E.coli 0157/H7, which can cause fatal disease.
- Some of its symptoms include bloody diarrhea, stomach cramps, vomiting and fever. Some E.coli can also cause respiratory illnesses and urinary tract infections.
Measurement:
- The drinking water treatment goal in the U.S. is to achieve no detectable coliform or fecal or E.coli bacteria per 100 mL of sample. The traditional analytical methods have included multiple tube fermentation, 0.45 micron membrane filtration on a growth medium and incubation and counting colony formation in 24 to 48 hours.
- Simpler techniques have been introduced based upon release of a dye by enzymatic action of the growing microorganism (e.g. Colilert). The water sample is stored at 37o C for 24 hours. If the sample becomes yellow, coliforms are indicated; if it is fluorescent under a UV lamp, E. coli are indicated. Multiple Colilert sample tests can be used for quantitation, if desired, but presence/absence is usually a sufficient determination.
Water treatment:
- The principal conventional water treatment techniques that are effective for controlling pathogens and the indicator organisms are coagulation and filtration and disinfection and there are numerous variations, including choices of disinfectant, dosing levels and contact times.
- Slow sand filtration is effective. In addition, membrane technologies remove particles by size exclusion. Nanofiltration (~0.001 µm pore size) and reverse osmosis (~0.0001 µm) membranes can directly remove bacteria and viruses.
- The larger pored membranes, microfiltration (~0.1-1 µm) and ultrafiltration (~0.001 -0.1µm ) can also remove many microorganisms, including bacteria and viruses to a variable degree since the microorganisms are usually aggregated or adsorbed to particulates, or when the membranes are somewhat fouled.
- Conventional coagulation is expected to remove 1 or 2 logs of microorganisms. Potent disinfectants can inactivate up to 4 or more logs of microorganisms in a few minutes or less depending upon the concentrations, times and water temperatures (Ct values).
- Disinfection techniques using chlorine, ozone and chlorine dioxide are not very specific to particular bacteria and viruses so killing or inactivation of the coliform indicator microorganisms is a good indication of the concurrent elimination of any bacterial or viral pathogens that might be present. Coliforms are not good indicators of protozoa because they are more resistant to disinfection than are the bacterial indicators.
- Disinfection and water treatment as practiced does not produce sterile water. The purpose of water treatment is to assure that humans will not be exposed to an infectious dose of the pathogen by significantly reducing concentration of the pathogens that might be present.
Regulation:
- Coliforms, fecal coliforms and E. coli are present in source waters in amounts much greater than specific pathogens and their analyses are much simpler than for the pathogens. So, since they can be present in drinking water (and certainly wastewater) at least partly from fecal contamination, their detections have been used for many years as usually conservative water quality and treatment performance indicators and as process monitors.
- The expected minimum log removal performance of a surface water treatment facility is at least 4 logs of virus and bacteria up to 6 logs.
- Until April 15, 2013, the Maximum Contaminant Level (MCL) for total coliforms in the U.S. was 0/100 mL in at least 95 percent of the samples collected by a water supplier each month. No positive samples for fecal coliform or E.coli were allowed.
- The total coliform MCL (but not fecal coliforms or E. coli) was rescinded partly because data does not indicate a good correlation between total coliform detections and waterborne disease. This has been known for many years. The World Health Organization (WHO) eliminated total coliforms from its guidelines about 20 years ago.
- Now total coliforms are considered to be most likely indicative of a lack of proper O&M — usually in distribution. Follow up determinations of cause are required.
References: Revisions to the Total Coliforms Rule, FR 78, No.30, Feb. 13, 2013. CDC National Center for Emerging and Zoonotic Infectious Diseases. Breed RS, Conn HJ (May 1936).j. Bact. 31 (5): 517–8.
About the Author
Sign up for our eNewsletters
Get the latest news and updates